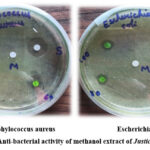

In Silico and In Vitro Analysis of Justicia adhatoda Methanol Extract: Molecular Docking Insights and A Promising Approach for Drug Discovery
Department of Chemistry, Holy Cross College, Tiruchirappalli, Tamil Nadu, India
Corresponding Author E-mail: angelpraba98@gmail.com
DOI : http://dx.doi.org/10.13005/ojc/410219
ABSTRACT:Plants are a natural repository for therapeutic compounds. These are practically completely free of adverse effects. For their primary medical requirements, around three-quarters of the world's population turns to traditional medicine, with a significant proportion of these remedies derived from plant-based extracts and bioactive compounds. These phytoconstituents were obtained from various plant sections. This study investigated the antimicrobial activity of methanol extract of Justicia adhatoda against E. coli and S. aureus, demonstrating concentration-dependent inhibition. GC-MS analysis revealed 20 bioactive phytochemicals, including 1,2-Dimethoxy-4-[2-Nitroethenyl] Benzene, which exhibited potential anti-inflammatory activity via molecular docking against Mitogen-Activated Protein Kinase (MAPK). Phytochemical characterization, UV, FT-IR, and quantitative analysis confirmed the presence of bioactive compounds. These findings suggest Justicia adhatoda's potential as a natural antimicrobial and anti-inflammatory agent.
KEYWORDS:Antimicrobial; GC-MS; Molecular docking; MAPK; phytochemicals
Introduction
Medicinal plants play a vital role in global healthcare, contributing significantly to therapeutic discoveries, economic growth, and societal well-being. Approximately 25% of modern medicines are derived from plants, improving health outcomes worldwide. Moreover, approximately 75% of people worldwide get their primary medical care from conventional medicine, primarily plant-based, despite variability in scientific validation1. The World Health Organization estimates two billion people depend heavily on medicinal plants. Increasing adoption of herbal products in developed countries presents opportunities and challenges, including toxicity risks. To address these concerns, the WHO established a Traditional Medicine Policy in 1991, publishing guidelines and monographs on widely used herbal medicines.
Challenges persist, including weak scientific evidence, suboptimal drug development practices and insufficient funding, hindering phytopharmaceutical innovation. Addressing these gaps requires integrating traditional knowledge with modern science, enhancing regulation and standardization, and investing in research. Phytochemicals, derived from secondary plant metabolites, serve as foundational components for efficacious medications2. Their pharmacological activities validate the scientific basis of modern medicine. Plant extracts exhibit diverse therapeutic properties, including antimicrobial, antimalarial, antioxidant, antidepressant, anti-aging, antiviral and anti-inflammatory effects3. Advanced drug testing employs molecular docking software, predicting binding interactions between bioactive compounds and target molecules4. This computational modelling technique forecasts three-dimensional structures and complexes.
In the present investigation, methanolic extraction of Justicia adhatoda leaves was performed using the Soxhlet method. Phytochemical investigation of the methanol extract identified a rich array of bioactive secondary metabolites. Further characterization was carried out using various analytical techniques. The secondary metabolites present in the extract demonstrated significant antimicrobial activity, suggesting that Justicia adhatoda may serve as a valuable natural reservoir for antibacterial compounds. Molecular docking studies revealed that 1,2-Dimethoxy-4-[2-Nitroethenyl] Benzene exhibits potent binding affinity towards Mitogen-Activated Protein Kinase (MAPK), indicating its potential as a novel anti-inflammatory agent.
Materials and Methods
Chemicals Used
Chemicals and materials acquired from Precision Scientific & Co. included methanol, TLC plates, silica gel, n-hexane and other solvents used for column.
Herb Sampling
Adhatoda leaves were collected from Ariyalur, Tamil Nadu, India, cleaned with tap water, shade-dried (15 days), and pulverized into a fine powder for phytochemical analysis and extraction.
 |
Figure 1: Leaves of Justicia adhatoda.Click here to View Figure |
Herbal Extract Preparation
A Soxhlet extraction apparatus was employed to extract the crushed leaf sample using methanol (99.9% purity). The extract was concentrated to dryness using a rotary evaporator (Buchi Rotavapor R-200) and stored in an airtight container at 4°C for further analysis.
 |
Figure 2: Methanol-soluble fraction of Justicia adhatoda.Click here to View Figure |
Characterization Techniques
Analytical methods for plant extract identification
Phytochemical analysis was performed, and the findings were noticed based on the color change or precipitate development with the addition of certain reagents. A preliminary phytochemical screening was conducted to detect secondary metabolites in plant extracts. For qualitative analysis, a stock solution was prepared by dissolving 0.5g concentrated plant sample in 100ml methanol. Phytochemical analysis of plant extracts involves the systematic identification and examination of bioactive chemical constituents as follows,
Table 1: Natural products analysis
| PHYTO CHEMICALS | TESTS |
| Terpenoids | Liebermann-Burchard Test |
| Alkaloids | Drage Dorff’s Test |
| Saponin | Froth Test |
| Tannins | Ferric Chloride Test |
| Flavonoids | Alkaline reagent test |
| Steroids | Salkowski Test |
| Coumarins | Sodium Hydroxide Test |
| Glycosides | Molisch’s Test |
| Xanthoproteins | Xanthoproteic Test |
| Phlobatannins | Precipitation Test |
| Phenol | Lead acetate Test |
| Cardiac glycosides | Legal’s Test |
| Carbohydrate | Fehling’s Test |
| Emodin | Magnesium-HCl Test |
| Anthraquinone | Koepp’s Test |
| Anthocyanin | Bate-smith Test |
UV-Visible Spectroscopy
The plant extract can be characterized using the UV spectrum by measuring the magnitude, peak wavelength, and spectral bandwidth of the light they absorb. After centrifuging the leftover plant extract solution for ten minutes at 8000 rpm, it was filtered. UV analysis was performed on the filtrate. The methanol extract of Justicia adhatoda was subjected to UV spectrum analysis and absorbance measurements were taken at ambient temperature using a Perkin Elmer Lambda 950 UV-Visible spectrophotometer with a slit width of 2 mm. The extract was analysed using UV and visible light with wavelengths between 200 and 800 nm.
Molecular Fingerprinting
The distinctive functional group of extract was identified using FT-IR. One feature of a chemical bond is the wavelength of light that is absorbed. It gives details about a molecule’s structure that are often gleaned from its absorption spectra. The Bruker infra-red spectrometer was used to get the infrared spectra. The scan range for the sample was 4000–400cm-1. Peak values were noted.
Mass Spectrometric Detection with Gas Chromatogram
GC-MS analysis was performed to characterize the phytochemical profile of the methanol extract of Justicia adhatoda in order to determine its chemical composition and the presence of active components. For GC-MS, the Shimadzu QP-2010 plus was used. The column was initially heated to 100℃ at a rate of 5℃/min, then increased further. The detection was carried out in full scan mode from m/z 40 to 650. By comparing the mass spectra of unknown peaks that were acquired with those that were stored at NIST (National Institutes of Standards and Technology), the compounds were identified.
Molecular Docking Study
The molecular docking study of 1,2-Dimethoxy-4-[2-Nitroethenyl] Benzene against Mitogen-activated Protein Kinase (MAPK) was conducted using Auto Dock 4.2.6, Auto Dock Vina, and BIOVIA Discovery Studio.
Ligand Preparation
The chemical structure of 1,2-Dimethoxy-4-[2-Nitroethenyl] Benzene was downloaded from PubChem and prepared for molecular docking simulations.
 |
Figure 3: 3D structure of 1,2-Dimethoxy-4-[2-Nitroethenyl] Benzene.Click here to View Figure |
Target Protein Preparation
The crystal structure of Mitogen-Activated Protein Kinase (PDB ID: 6G54) was obtained from the RCSB PDB and prepared for molecular docking simulations.
 |
Figure 4: Structure of Target ProteinClick here to View Figure |
Pharmacotherapeutic Effects
Inhibitory Effects of Plant Extract against Micro-organisms
The study utilized E. coli (MTCC 443) and S. aureus (MTCC 87) cultures, which were procured from MTCC, Chandigarh, India. In order to assess antibacterial activity, agar Mueller-Hinton medium, filter paper discs, and sample concentrations (60, 80, 100 µg/mL) were prepared. Amoxicillin (5 µg) served as positive control. Disc diffusion assay involved inoculating 10 mL Mueller-Hinton agar with test organisms in sterile 60 mm petri dishes. Filter paper discs loaded with sample and amoxicillin were placed atop. Screens were incubated for a whole day at 37°C, and the inhibitory zones were measured in millimetres. The experiments were conducted in duplicate to ensure reproducibility.
Results and Discussions
Qualitative analysis of plant extract
In this study, methanol extracts of Justicia adhatoda leaves underwent comprehensive phytochemical screening. The presence or absence of phytochemicals was denoted by “+” (positive) or “-” (negative) signs, respectively (Table 1). Results revealed abundant terpenoids, flavonoids and alkaloids, moderate levels of tannins and xanthoproteins, and trace amounts of coumarins, steroids, saponins and cardiac glycosides. Conversely, phlobatannins, anthraquinone, emodin, phenol, carbohydrates, anthocyanin and glycosides were undetectable.
Table 2: Qualitative phytochemical evaluation of Justicia adhatoda methanol extract
| S.NO | PHYTOCHEMICAL CONSTITUENTS | PLANT EXTRACT |
| 1 | Terpenoid | +++ |
| 2 | Flavonoids | +++ |
| 3 | Saponin | + |
| 4 | Tannin | ++ |
| 5 | Alkaloids | +++ |
| 6 | Steroids | + |
| 7 | Glycosides | – |
| 8 | Phlobatannins | – |
| 9 | Coumarins | + |
| 10 | Emodin | – |
| 11 | Anthraquinone | – |
| 12 | Anthocyanin | – |
| 13 | Carbohydrate | – |
| 14 | Cardiac glycosides | + |
| 15 | Xantho protein | ++ |
| 16 | Phenol | – |
To further elucidate the molecular characteristics, GC-MS analysis was carried out. This facilitated determination of molecular weights and fragmentation patterns, providing invaluable insights into phytochemical structures. These bioactive compounds contribute to Justicia adhatoda’s distinctive biological activities, warranting further investigation for potential pharmacological applications.
 |
Figure 5: Qualitative phytochemical evaluation of Justicia adhatoda leaf extract of methanolClick here to View Figure |
UV-Visible Spectrophotometry
Medicinal plant extracts are renowned for their intricate biochemical composition, necessitating the employment of comprehensive analytical techniques to unravel their phytochemical secrets. UV-visible spectroscopy, a quantitative analytical technique, has been utilized in this study to investigate the chemical properties and phytoconstituents of medicinal plant extracts by assessing light absorption and transmission.
The UV-visible spectrum of the plant extract revealed a plethora of absorption peaks, providing invaluable insights into the molecular structure and functional groups present. The UV region (200-400 nm) exhibited absorption peaks indicative of unsaturated groups, aromatic compounds, and heteroatoms (S, N, O). The visible region peaks (400-800 nm) suggested the presence of chromophores (alkene, imine, carbonyl, azo, nitro, nitroso) with delocalized π electrons.
 |
Figure 6: UV spectroscopy of methanol leaf extract of Justicia adhatoda.Click here to View Figure |
Notably, the spectrum displayed absorption maxima at 273 nm (0.51 AU), characteristic of aromatic compounds featuring benzene rings. The peak at 423 nm (0.18 AU) was indicative of nitro groups (-NO2) undergoing n→π* electronic transitions. Furthermore, the absorption maximum at 665 nm (0.07 AU) suggested the presence of N-oxides (-N=O) with n→π* transitions, displaying a hypochromic shift.
These findings demonstrate the potential of UV-visible spectroscopy in identifying bioactive compounds in medicinal plant extracts. The presence of aromatic compounds, nitro groups, and N-oxides suggests that the plant extract may possess antioxidant, anti-inflammatory, and antimicrobial properties, warranting further investigation into its therapeutic potential.
Molecular Fingerprinting
The FT-IR spectroscopy analysis of Justicia adhatoda extract leaves revealed a complex phytochemical profile, identifying seven distinct functional groups. Notably, the broad, intense peak at 3388.55 cm-1 indicated the presence of amine groups, characterized by stretching vibrations. Additionally, sharp peaks at 2525.64, 2838.23, 2866.39, and 2947.48 cm-1 signified hydroxyl (O-H) stretching, while the peak at 1052.57 cm-1 confirmed primary alcohol presence. The signal at 1411cm-1 shows O-H bending. Prominent signals at 1647.19 and 1112.58 cm-1 were attributed to carbonyl compounds’ frequency vibrations. Furthermore, broad peaks at 657.03 and 1453.90 cm-1 indicated C-H bending vibrations. These findings demonstrate the diversity of phytochemical constituents in Justicia adhatoda methanol leaf extract, underscoring its potential therapeutic significance.
 |
Figure 7: FT-IR spectroscopy of methanol leaf extract of Justicia adhatoda.Click here to View Figure |
Mass Spectrometric Detection with Gas Chromatogram
The methanol extract of Justicia adhatoda was subjected to GC-MS analysis to identify and quantify the bioactive compounds present in the plant. The chromatogram revealed 18 distinct peaks, corresponding to various phytochemicals.
 |
Figure 8: GC-MS of methanol leaf extract of Justicia adhatoda.Click here to View Figure |
The corresponding chromatogram (Fig-8) and comprehensive table (Table-2) shows the detailed retention times, molecular formulas, molecular weights, and concentrations of detected compounds.
Table 3: GC-MS-Based Metabolite Profiling of Justicia adhatoda Leaf Methanol Extract
| Peak | Retention time(min) | Area % | Height % | Name |
| 1 | 9.985 | 5.36 | 7.32 | BENZOIC ACID |
| 2 | 13.914 | 14.9 | 14.2 | CYCLOHEXASILOXANE, DODECAMETHYL- |
| 3 | 17.53 | 2.81 | 4 | PENTALENONE |
| 4 | 34.852 | 17.28 | 12.75 | BIS(2-ETHYLHEXYL) PHTHALATE |
| 5 | 35.797 | 2.7 | 3.63 | 2-CYCLOBUTEN-1-ONE |
| 6 | 39.33 | 2.96 | 3.4 | 1,2-DIMETHOXY-4-[2-NITROETHENYL] BENZENE |
| 7 | 39.36 | 2.09 | 3.24 | 4-METHYL-1H-PYRANOLO[4,3-C] PYRIDINE |
| 8 | 39.402 | 3.4 | 3.28 | 4-(PENTADEUTERIO)PHENYLAZULENE |
| 9 | 39.554 | 3.47 | 4.28 | 4-METHYL-1H-PYRANOLO[4,3-C] PYRIDINE |
| 10 | 39.61 | 5.09 | 4.82 | 1,5,7-TRIMETHYL-3-OXO-2-OXA BICYCLO [4.2.0] OCT-4-ENE-(ENDO)-7-CARBONITRILE |
| 11 | 39.64 | 2.33 | 4.37 | 12-AZA BICYCLO (9.2.1) TETRADECA-1(14)-ENE-13-ONE |
| 12 | 39.675 | 2.66 | 4.4 | 12-AZA BI CYCLO (9.2.1) TETRADECA-1(14)-ENE-13-ONE |
| 13 | 39.737 | 5.04 | 4.52 | 12-AZA BI CYCLO (9.2.1) TETRA DECA-1(14)-ENE-13-ONE |
| 14 | 39.875 | 4.49 | 3.36 | TRANS-1-ACETOXY-4-(TRIFLUOROACETOXY)-2-CYCLOHEXENE |
| 15 | 40.01 | 8.48 | 3.27 | TRANS-1-ACETOXY-4-(TRIFLUOROACETOXY)-2-CYCLOHEXENE |
| 16 | 40.07 | 1.88 | 3.63 | 4-METHYL-1H-PYRANOLO[4,3-C] PYRIDINE |
| 17 | 40.103 | 2.61 | 3.96 | 3-PHENYL-3-(1,1-DIMETHOXYPHOSPHINYL-1,2-DIHYDRO-2-ISOQUINOYL) PHTHALIDE ISOMER |
| 18 | 40.155 | 3.51 | 3.91 | 4,5,6-TRICHLORO-3-PYRIDAZINECARBONITRILE |
The GC-MS analysis revealed a diverse range of phytochemicals, including benzoic acid, cyclohexasiloxane, pentalenone, bis(2-ethylhexyl) phthalate, and 1,2-dimethoxy-4-[2-nitroethenyl ]benzene. The presence of these compounds suggests that Justicai adhatoda possesses potential medicinal properties, including anti-inflammatory, antimicrobial, and antioxidant activities.
The identification of 1,2-dimethoxy-4-[2-nitroethenyl ]benzene, a compound with reported anti-inflammatory and antioxidant properties, is particularly noteworthy. This compound may contribute to the plant’s traditional use in treating respiratory disorders, such as bronchitis and asthma.
The presence of pentalenone, a compound with reported antimicrobial properties, may also contribute to the plant’s traditional use in treating infections.
Molecular Interaction Modeling
Unveiling the Molecular Binding Mechanisms of 1,2-Dimethoxy-4-[2-Nitroethenyl] Benzene with MAPK:
A thorough molecular docking analysis of the complex formed between MAPK (PDB ID: 6G54) and 1,2-Dimethoxy-4-[2-Nitroethenyl] Benzene (PubChem CID: 53960700) has revealed a remarkably strong binding affinity of -6.7 kcal/mol. This robust interaction is facilitated by a trio of conventional hydrogen bonds with LYS (A) 114, situated within the H-bond donor region, at distances of 2.83 Å, 2.73 Å, and 2.67 Å.
Furthermore, hydrophobic alkyl bonds are observed with VAL (A) 39, LYS (A) 54, and LYS (A) 114 at 4.46 Å, 4.81 Å, and 5.47 Å, respectively. Additionally, TYR (A) 113 forms a hydrophobic pi-alkyl bond at 4.81 Å. These interactions occur spatially between aromatic faces and edges, within hydrophobic regions.
Notably, LYS (A) 114 exhibits basic ionizability, while hydrogen bonds display neutral interpolated charges (0.067). Solvent accessibility surface values range from 10.0 to 25.0 for LYS (A) 54, VAL (A) 39, TYR (A) 113, and LYS (A) 114, indicating varied solvent exposure.
This comprehensive analysis provides invaluable insights into the molecular interactions driving the binding affinity of 1,2-Dimethoxy-4-[2-Nitroethenyl] Benzene with MAPK1. These findings inform potential inhibitory mechanisms, underscoring the significance of this molecular complex in the pursuit of novel therapeutic strategies.
 |
Figure 9: 2D interaction of target protein with ligandClick here to View Figure |
This illustration provides a visual representation of the molecular interactions between MAPK1 and 1,2-Dimethoxy-4-[2-Nitroethenyl] Benzene, highlighting the hydrogen bonds, hydrophobic alkyl bonds, and pi-alkyl bonds that contribute to the robust binding affinity.
 |
Figure 10: 3D interaction of 1,2-Dimethoxy-4-[2-Nitroethenyl] Benzene against MAPK. Click here to View Figure |
Inhibitory Effects of Palnt Extract Against Micro-Organisms
The quest for novel antibacterial agents has led researchers to explore the vast realm of plant secondary metabolites, renowned for their profound medicinal properties. This study aimed to evaluate the antibacterial efficacy of a methanol plant extract against two formidable pathogens, Escherichia coli (E. coli) and Staphylococcus aureus (S. aureus).
The antibacterial activity of the methanol plant extract was assessed using the disk diffusion method, with concentrations ranging from 60-100 µg/mL. The results revealed a concentration-dependent inhibitory effect, with the extract producing notable inhibition zones of 1-3 mm and 2-4 mm against E. coli and S. aureus, respectively.
In contrast, the standard antibiotic Amoxicillin exhibited a pronounced inhibition zone of 12 mm, serving as a benchmark for comparison. However, the plant extract demonstrated a dose-dependent response, where elevated concentrations yielded enhanced inhibition rates. This positive correlation underscores the extract’s potent antibacterial properties, warranting further exploration into its therapeutic potential.
Table 4: Inhibition rate of Methanol plant extract
| Samples | Concentration(µg/ml) | Organisms/Inhibition zone(mm) | |
| S. aureus | E. coli | ||
| Samples
|
60 | 2 | 1 |
| 80 | 3 | 2 | |
| 100 | 4 | 3 | |
| Standard Amoxicillin | 10 µl/disc | 12 | 10 |
| Methanol | 10 µl/disc | 0 | 0 |
|
Figure 12: Anti-bacterial activity of methanol extract of Justicia adhatoda.Click here to View Figure |
Conclusion
The methanol plant extract was found to possess a complex mixture of bioactive phytoconstituents, as revealed by preliminary phytochemical screening, predominantly alkaloids, flavonoids, tannins, saponins and terpenoids. UV-Visible spectroscopy identified absorption peaks at 273.7, 423.6 and 665.7 nm, indicating diverse chromophore structures. The FT-IR spectrum exhibited a characteristic absorption band corresponding to the hydroxyl (O-H) functional group, confirming its presence. GC-MS analysis elucidated phytochemical constituents, retention times, molecular formulas and weights. Notably, 1,2-Dimethoxy-4- Benzene exhibited potent binding affinity (-5.6 kcal/mol) with Mitogen-Activated Protein Kinase (MAPK), forming two hydrogen bonds with LYS 54 (A) at 2.49Å and 2.52Å, indicating potential drug-like properties. A significant antibacterial effect was observed with the methanol extract, particularly in inhibiting the growth of Staphylococcus aureus surpassing E. coli inhibition rates, underscoring its therapeutic potential as an efficient antimicrobial agent.
Acknowledgement
The authors are deeply indebted to the management of Holy Cross College, Tiruchirappalli, for providing the necessary laboratory infrastructure to facilitate this study.
Funding Sources
The author(s) received no financial support for the research, authorship, and/or publication of this article.
Conflict of Interest
The author(s) do not have any conflict of interest.
Data Availability Statement
This statement does not apply to this article.
Ethics Statement
This research did not involve human participants, animal subjects, or any material that requires ethical approval.
References
- Annika Maria, P.; Anish, N.A.G. Notulae Scientia Biologicae. 2023, 15(3), 11625-11625.
CrossRef - Ameer, M.R.; Moghul, N.B.; Ambreen Javed, Azhar Butt, M.; Abbas, H.B.; Khalid, Z.M.; Khan Khattak, J.Z.; Mubin Mustafa Kiyani. Alternative Therapies in Health & Medicine. 2023, 29(7).
- Shipra Shukla.; Satisha Hegde.; Anil Kumar.; Gaurav Chaudhary.; SK Tewari.; DK Upreti.; Mahesh Pal. Journal of Essential Oil-Bearing Plants. 2017, 20(1), 116-122.
CrossRef - Regis Freeda, R.; Jeni Chandar Padua. Cross Res. 2022, 13(2).
- Alka Sharma.; Ashwani Kumar. World J Pharm Sci. 2016, 5, 1332-1341.
- Mathiyazhagan, N.; Devarajan, N.; Geetha Priyadharshini, S.; Sabariswaran, K.; Sabarathinam, S.; Amal, S.; Hesham Almoallim, S.; Arivalagan Pugazhendhi. Inorganic Chemistry Communications. 2021, 134, 109071.
CrossRef - Alka Sharma.; Ashwani Kumar. World Journal of Pharmaceutical Research. 2016, 5(7), 1674-1704.
- Rajeshkumar, S.; Santhoshkumar, J.; Senthil Kumar, P.; Saravanan, A.; Tharani, M. Applied Nanoscience. 2023, 13(6), 3993-4004.
CrossRef - Mithun Rudrapal.; Sugumari Vallinayagam.; Sahar Aldosari.; Johra Khan.; Hind Albadrani.; Alaa Al-Shareeda.; Mehnaz Kamal. Frontiers in Nutrition. 2023, 10, 1161471.
CrossRef - Thombre, N.A.; Bhadane, R.G.; Ahire, P.S. IJBPAS. 2022, 11(11): 5459-5472.
- Narasimhan, D.; Irwin, S. J. Rheeda, 2011, 21, 87–105.
CrossRef - Gocan, S.; Cimpan, G. Journal of Liquid Chromatography & Related Technologies, 2004, 27, 1377–1411.
CrossRef - Raaman, N. Phytochemical Techniques. (New India Publishing Agency, 2006).
CrossRef - Parth Trivedi, B.; Madhavi Badole, R. OJCHEG 2024, 40(5): 1506-1512.
CrossRef - Newman, D.J.; Cragg, G.M. Journal of Natural Products. 2016, 79, 3-5.
CrossRef - Rates, S.M. Toxicon. 2001, 39, 5-6.
CrossRef - Morris, G.M. Journal of Computational Chemistry. 2009, 30, 16-18.
- Kinmoladun, A.C.; Ibukun, E.O.; Afor, E. African Journal of Biotechnology. 2007, 6, 10-12.
- Khoddami, A.; Wilkes, M.A.; Roberts, T.H. Molecules. 2013, 18, 2-5.
CrossRef - Muhammad Nasir.; Roha Ramash.; Hira Fatima.; Sana Ashraf.; Iqra Munir.; Sundas Asghar.; Muhammad Adnan.; Atifa Masood.; Sunbal Khalil Chaudhari. Scientifica. 2024, 2024(1), 1374346.
Abbreviations
UV- Ultra-Violet.
FT-IR- Fourier Transform Infrared.
GC-MS- Gas Chromatography- Mass spectrometry.
MAPK- Mitogen Activated Protein Kinase.
PDB- Protein Database.
RCSB- Research Collaboratory for Structural Bioinformatics.
MTCC- Microbial Type Culture Collection.
AU- Absorbance Unit.
LYS- Lysine
VAL-Valine
TYR- Tyrosine
SAS- Solvent Accessible Surface
Accepted on: 01 Apr 2025
Second Review by: Dr. Majid Khan
Final Approval by: Dr. Abdelwahab Omri

















